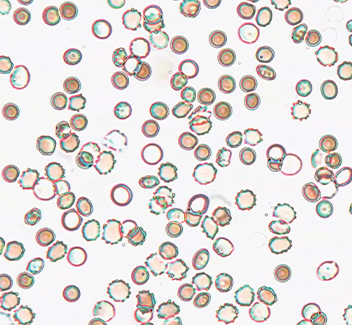

Phantom KT840

搭载 420 万像素 BSI 传感器,捕捉超高速运动
Phantom KT840 采用 420 万像素背照式(BSI)传感器,可实现高达 1,850 fps 的精准高速成像。它是流体动力学、冲击物理学及关键运动跟踪等应用的理想选择。
| 1,850 fps | 222,220 fps | 88.7% | 450 ns* |
|---|---|---|---|
| 2560 x 1664 | 512 x 64 | QExFF(黑白) | *安装 FAST 选件时(受出口管制) |
| 420 万像素分辨率 | 最大帧速率 | 量子效率 | 最小曝光时间 |
KT840 帧速率表
| 分辨率 (宽 x 高) |
2560 x 1664 | 2560 x 1024 | 2560 x 512 | 2048 x 128 | 1536 x 64 | 1024 x 32 |
|---|---|---|---|---|---|---|
| 最大帧速率 (fps) |
1,850 | 3,010 | 6,020 | 29,520 | 77,660 | 222,220 (安装 FAST 选件时) |
| 分辨率 (宽 x 高) |
1280 x 832 Binned | 768 x 768 Binned | 768 x 640 Binned | 1024 x 256 Binned | 512 x 128 Binned | 512 x 64 Binned |
|---|---|---|---|---|---|---|
| 最大帧速率 (fps) |
7,420 | 13,170 | 15,810 | 29,520 | 115,940 | 222,220 (安装 FAST 选件时) |
使用帧速率和录制时间计算器查看其他可用的像素分辨率和帧速率组合以及对应的记录时间。

KT840 专为先进的科学成像而设计,可以在高帧速率下捕获 420 万像素分辨率,是分析微小细节和快速运动片段的理想选择。小巧紧凑的 3.2 kg 机身降低了设置的复杂性,使其非常适合用于紧凑的实验室空间和复杂的实验配置中。
- 无缝集成:可编程 I/O 可以根据研究需求精确定制触发和同步。
- 高级功能:使用极限动态范围(EDR)捕获非凡的细节,可以有效地管理发光事件的像素饱和度。
- 简化的工程流程:使用基于图像的自动触发(IBAT),多片段分区和 PCC 软件中的连续记录功能以节省时间。

KT840 在具有挑战性的照明条件下的科学应用中表现出色,包括流体动力学、生物力学和微流控。其高分辨率和极低的运动模糊特性,使其成为精准捕捉高速运动现象的理想选择。
- 在现场远程操作:使用摄像机控制界面,并保存到可移动的 CF-Express 卡,以实现独立且不受限制的工作流程。
- 标准 10Gb 以太网:通过 PCC 软件实现可靠控制和高效下载。
- 专为科学成像而设计:由于传感器的先进设计,KT840 在光线有限的高级科学应用中表现出色。

Phantom KT840 采用专有的 2560 x 1664 像素 BSI 传感器,专为低光环境下的科学运动捕捉而设计。由于光子可直接达到光电二极管,该传感器能实现卓越的量子效率与像素响应。KT840 通过 EMVA 1288 标准认证,能够为流体动力学、生物力学和材料研究应用提供稳定可靠的性能。
- BSI 传感器结构可实现 88.7%(黑白)的 QexFF(量子效率x 填充因数)。
- Binned 模式在 1280 x 832 及更低分辨率下合并像素以提高帧速率和改善纵横比。
- 无与伦比的性能标准:遵循 EMVA 1288 标准的综合性测试报告明确验证了传感器的卓越性能,表明其在挑战性的光线条件下具有出色的像素响应。
用于运动分析的精密成像解决方案
| 最小化运动模糊 | 低至 450 ns的曝光时间可消除运动模糊 |
| 卓越的分辨率 | 高传感器分辨率可在生成的图像中提供卓越的空间分辨率 |
| 与科学成像平台集成 | 与行业标准软件包兼容,实现无缝集成的工作流 |
| 原始数据 = 精准洞察 | 通过完全控制校正设置可获得未处理的图像文件,适用于 DIC 和定制化分析 |
高速成像应用和技术
关键配件
- 带定制泡沫的手提箱
- 两个 I/O 端口所需的 RDIO 电缆 (单独出售)
- CF Express 卡和读卡器
- 触发开关(BNC 触发器)
- 支持尼康 F、佳能 EF、C 和 M42 的镜头接口

功能强大的运动分析软件
我们的软件套件通过两款关键应用程序最大限度地发挥了 Phantom 高速摄像机的性能。Phantom 摄像机控制(PCC)软件处理摄像机操作,记录参数控制和文件转换。Phantom Cine Analyzer(PCA)软件提供具有二维对象跟踪、亚像素精度测量和自动报告功能的高级运动分析。
通过我们的 SDK,这两款应用程序都能与 Python、MATLAB 和 LabVIEW 等分析平台集成,使用户能够创建自定义应用程序,并利用现有的工作流程为跨行业的应用提供服务。
联系我们
如果您对高速成像应用有任何疑问或需要帮助,请随时与我们联系并讨论您的成像需求、演示请求以及获得技术支持,我们期待与您一同探索更多可能。